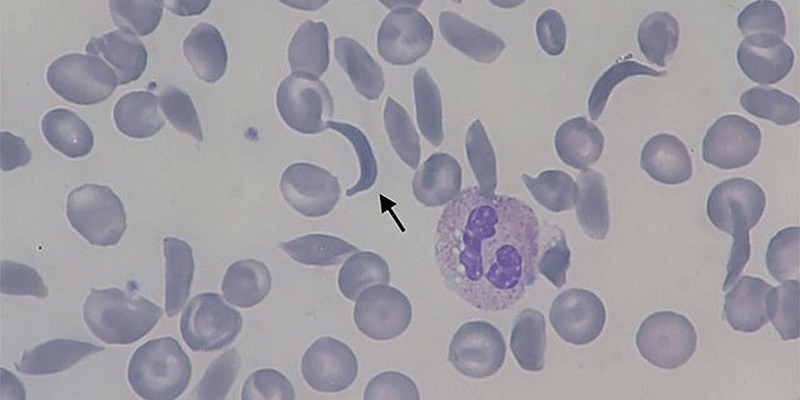
Arrow points to the sickle cells that cause the blood disorder.

Cell & Gene Therapy
|
Alex Sargent, PhD
CRISPR Silences Sickle Cell
Recent approvals of a novel treatment using CRISPR bring new hope to patients, but also raise new challenges
Both US and European regulators green-lighted the first therapy to use the gene editing technology known as CRISPR. This momentous decision stands to go down in scientific history as a milestone in bringing the promise of CRISPR and gene editing technologies to the forefront of modern medicine. Will gene editing ever be the same? The therapy – marketed as Exa-cel in the US and Casgevy in Europe – is a first-of-its-kind cell-based therapy for sickle cell anemia born out of a partnership between Vertex Pharmaceuticals and CRISPR Therapeutics.1 As the first therapy to successfully take the Nobel prize-winning science of CRISPR into clinical trials and through commercial approval, this groundbreaking treatment has garnered much hype and hope.
Perhaps most hopeful are the more than 100,000 patients in the US and Europe suffering from sickle cell anemia (SCA),2 a genetic blood disorder where abnormal mutations in certain genes negatively affect the form and function of red blood cells, in some cases giving the cells an abnormal sickle-like shape for which the disease is named. The mutations in red blood cells prevent the cells from producing the right amount of a crucial protein called hemoglobin, which red blood cells use to transport oxygen throughout the body. SCA can be an enormously painful and debilitating, with patients in and out of the hospital throughout their lives due to the excruciating pain the disease causes and a median life expectancy of less than 50 years.3 As a genetic condition it is most prevalent in persons of color, with about 1 in 12 African Americans possessing at least one mutation that can confer the disease.4
Figure 1. The sickle shaped blood cells which give the disease sickle cell anemia its name. Image courtesy of Paulo Henrique Orlandi Mourao, from Creative Commons: https://commons.wikimedia.org/wiki/File:Sickle-cell_smear_2015-09-10.jpg.
Through the gene editing technology of CRISPR DNA can be rewritten to reverse SCA. The therapy starts by collecting stem cells from the blood of SCA patients. These stem calls, called hematopoietic stem cells, can be enriched from the patient’s blood, and can then undergo genetic engineering using CRISPR. The cells are first carefully electrocuted in a controlled process known as electroporation to open tiny, microscopic pores into their membrane.5 Prior to those pores closing, a key CRISPR enzyme known as Cas9 is added to the cells so that it may traverse through the pores and into the cell to do its very important job. Cas9 is a type of enzyme known as an exonuclease, it cuts or cleaves DNA. As part of the CRISPR process Cas9 cuts DNA at very specific sites in the genome based on where its molecular guide tells it to cut. The molecular guide is fittingly referred to as the guide RNA, and for this therapy it specifically directs Cas9 to cut the DNA at a gene called Bcl11A.6
By cutting the DNA at this gene it turns off or “silences” the gene in these stem cells. This is important because Bcl11A is an inhibitor of certain types of hemoglobin, the crucial oxygen transporting protein that is lacking in patients with SCA. By silencing the Bcl11A gene CRISPR increases hemoglobin production in these stem cells and consequently all red blood cells that these stem cells produce. Once infused back into the patient, the genetically engineered stem cells engraft and continue to produce red blood cells that make higher levels of hemoglobin. In clinical trials with SCA patients receiving this therapy, over 90% of patients no longer required hospitalization for pain or other SCA symptoms after treatment.6 This therapy dramatically improves the quality of life for patients who received it, and it could well represent a potential cure for this debilitating disease.
As more patients are treated with this newly approved therapy, there are questions and challenges that remain. One is the high cost of the therapy, which is reported to be just over two million dollars per patient.7 Considering that over 80% of SCA patients live in developing nations fighting severe poverty, it will be imperative to look at new technologies and methods to reduce the overall cost and complexity of manufacturing this therapy.3 Another concern is the long-term safety of this CRISPR based therapy. While Cas9 has been engineered to cut at a very specific site in the genome, there is concern of erroneous or “off- target” cuts in the DNA by Cas9 at other genes. This could cause potentially serious and life-threatening side effects. While data from clinical trials supports a strong safety profile of this therapy with minimal risk of off-target cuts by Cas9, it will be important to continually monitor patients that receive this therapy to make sure the risk stays very low.6 Before the scientific community can claim success in using CRISPR to fight disease, many more years of clinical and experimental data will be needed to ensure we fully understand the risks this technology brings.
This new CRISPR-based therapy may well usher in the dawn of a new age where genetic engineering can halt disease and bring cures to patients. After approval to treat SCA, Vertex and CRISPR Therapeutics are already seeking approval from regulatory agencies to offer this therapy to treat another serious blood disorder known as beta thalassemia. It is worth noting that on the day the FDA granted approval to Exa-Cel for the treatment of SCA, it also granted approval to a different drug from BlueBird Bio called Lyfgenia to treat the same disease.8 Lyfgenia is similar in principle but uses a type of virus known as a lentivirus to genetically engineer blood cells, a process which has been described in the Eureka blog previously.9 No matter how you cut it, gene editing holds tremendous promise to patients suffering from genetic disease. By rewriting DNA we can rewrite history and hopefully make diseases that plague us today a thing of the past.
References
1. Vertex and CRISPR therapeutics announce US FDA approval of CASGEVYTM (Exagamglogene Autotemcel) for the treatment of sickle cell disease. Business Wire. (2023, December 8). https://www.businesswire.com/news/home/20231208951733/en/
2. Hassell KL. Population estimates of sickle cell disease in the U.S. Am J Prev Med. 2010 Apr;38(4 Suppl):S512-21. doi: 10.1016/j.amepre.2009.12.022. PMID: 20331952.
3. Lubeck D, Agodoa I, Bhakta N, Danese M, Pappu K, Howard R, Gleeson M, Halperin M, Lanzkron S. Estimated Life Expectancy and Income of Patients With Sickle Cell Disease Compared With Those Without Sickle Cell Disease. JAMA Netw Open. 2019 Nov 1;2(11):e1915374. doi: 10.1001/jamanetworkopen.2019.15374. PMID: 31730182; PMCID: PMC6902797.
4. Sedrak A, Kondamudi NP. Sickle Cell Disease. 2023 Aug 28. In: StatPearls [Internet]. Treasure Island (FL): StatPearls Publishing; 2023 Jan–. PMID: 29494006.
5. MaxCyte signs strategic platform license with Vertex Pharmaceuticals to advance CRISPR/Cas9-based gene-editing program. MaxCyte Inc. (2022, September 28). https://investors.maxcyte.com/news-releases/news-release-details/maxcyte-signs-strategic-platform-license-vertex-pharmaceuticals.
6. Frangoul H, et al. CRISPR-Cas9 Gene Editing for Sickle Cell Disease and β-Thalassemia. N Engl J Med. 2021 Jan 21;384(3):252-260. doi: 10.1056/NEJMoa2031054. Epub 2020 Dec 5. PMID: 33283989.
7. Angelica Peebles. (2023, December 7). U.S. poised to approve first gene-editing treatment in breakthrough for sickle cell patients. CNBC. https://www.cnbc.com/2023/12/07/crispr-gene-editing-treatment-us-approval.html#:~:text=Exa%2Dcel%20would%20be%20the,around%20%242%20million%20per%20patient.
8. Bluebird Bio announces FDA approval of LyfgeniaTM (lovotibeglogene autotemcel) for patients ages 12 and older with sickle cell disease and a history of vaso-occlusive events. bluebird bio, Inc. (2023). https://investor.bluebirdbio.com/news-releases/news-release-details/bluebird-bio-announces-fda-approval-lyfgeniatm-lovotibeglogene.
9. Sargent, A. (2023). Leveraging lentivirus | eureka blog - charles river laboratories. Eureka Blog. https://www.criver.com/eureka/leveraging-lentivirus.
-- Alex Sargent, PhD, Director of Process Development, C>, Charles River
